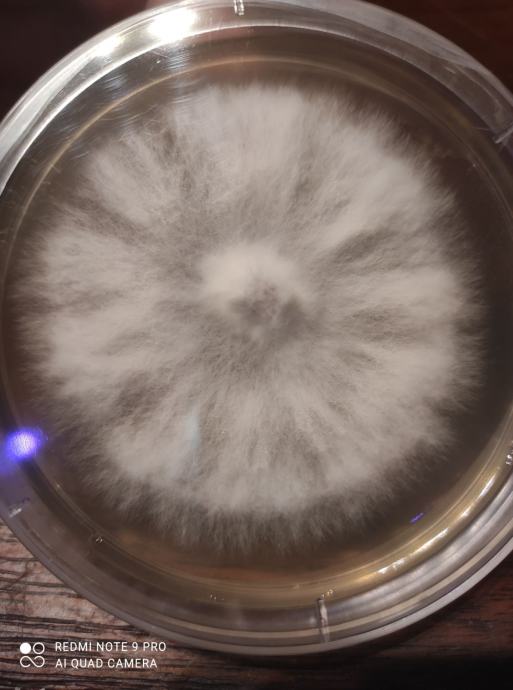

Osnovne informacije
- Lokacija
- Slovenija
- Cijena se odnosi na
- komad
Opis oglasa
Prodajemo svježi micelij na drvenim ćepovima, vrhunske kvalitete, za uzgoj sledećih sorta ljekovitih gljiva:
* Bukovaća (Pleurotus Ostreatus) variacije (siva, plava, žuta, roza, ljetna i kraljeva).
* Šitake (Lentinula Edodes)
* Lavja griva (Hericium Erinaceus)
* Reishi (Ganoderma lucidum)
* Ćuranov rep (Trameres Versicolor) i druge (Šimeji, Maitake, King Stropharia...)
Micelij se koristi za inokulaciju oblica. Čuva se u frižideru, rok trajanja minimalno 6 mjeseci. Imamo preko 20 sorti, zato nazovite za više detajla. Osim micelija na ćepovima, kod nas možete kupiti i micelij na žitu, micelij u petrijevi posudi i tekući micelij, kao i sve sto vam treba za uzgoj gljiva (vrece sa filterom, več pripremljeni substrati, sterilizirano žito u vreći sa injekcijskim ulazom...
Više informacija na;
00 386 40 57 44 88 (Viber, Whatsapp, Telegram, Signal ili Messenger) ili
Info@hisagob.si
Cijena ćepova:
100 kom = 15€
300 kom = 40€
500 kom = 55€
Postarina za HR do 5,0kg iznosi 10,5€, za narudzbe 100€+ postarinu platimo mi!
Pogledajte i ostale nase oglase!!!
Pratite nas na Facebooku https://www.facebook.com/profile.php?id=100075953180609
* Bukovaća (Pleurotus Ostreatus) variacije (siva, plava, žuta, roza, ljetna i kraljeva).
* Šitake (Lentinula Edodes)
* Lavja griva (Hericium Erinaceus)
* Reishi (Ganoderma lucidum)
* Ćuranov rep (Trameres Versicolor) i druge (Šimeji, Maitake, King Stropharia...)
Micelij se koristi za inokulaciju oblica. Čuva se u frižideru, rok trajanja minimalno 6 mjeseci. Imamo preko 20 sorti, zato nazovite za više detajla. Osim micelija na ćepovima, kod nas možete kupiti i micelij na žitu, micelij u petrijevi posudi i tekući micelij, kao i sve sto vam treba za uzgoj gljiva (vrece sa filterom, več pripremljeni substrati, sterilizirano žito u vreći sa injekcijskim ulazom...
Više informacija na;
00 386 40 57 44 88 (Viber, Whatsapp, Telegram, Signal ili Messenger) ili
Info@hisagob.si
Cijena ćepova:
100 kom = 15€
300 kom = 40€
500 kom = 55€
Postarina za HR do 5,0kg iznosi 10,5€, za narudzbe 100€+ postarinu platimo mi!
Pogledajte i ostale nase oglase!!!
Pratite nas na Facebooku https://www.facebook.com/profile.php?id=100075953180609
Karta
Napomena: Prikazana je točna lokacija
uzilainen
Svi oglasi ovog oglašivača
Korisnik je verificirao broj telefona u državi: Slovenia
Korisnik nije trgovac te na njega nisu primjenjive EU odredbe o zaštiti potrošača
- Adresa: 8210 Trebnje, Slovenia, Slovenia
-
- Oglas objavljen
- 11.04.2026. u 00:41
- Do isteka još
- Oglas prikazan
- 9722 puta
uzilainen
Svi oglasi ovog oglašivača
Korisnik je verificirao broj telefona u državi: Slovenia
Korisnik nije trgovac te na njega nisu primjenjive EU odredbe o zaštiti potrošača
- Adresa: 8210 Trebnje, Slovenia, Slovenia
-